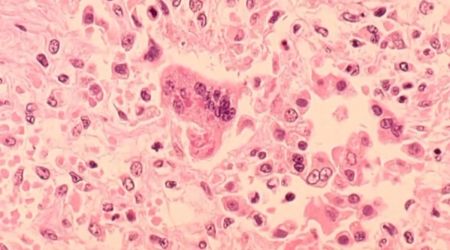

加拿大多伦多皮尔逊机场爆"高传染性"病毒,已致加拿大6省1死138患病。卫生局急发警告:出现症状不要上班、上学。皮尔区公共卫生局(Peel Public Health,PPH)提醒近期旅行的旅客,他们有可能在多伦多皮尔逊机场以及土耳其航空公司(Turkish Airlines)的两架航班上接触过麻疹病毒。

图源:51记者拍摄
该卫生机构在周四(11月12日)发布的一份新闻稿中证实,本周二确认了一例麻疹病例,患者有“近期有国际旅行史”,曾于12月4日从土耳其飞抵多伦多。PPH表示,12月4日搭乘土耳其航空TK707航班从喀布尔飞往伊斯坦布尔,以及同一天搭乘TK17航班从伊斯坦布尔飞往多伦多的所有乘客,都可能接触过麻疹病毒。PPH还警告称,12月4日晚上6:45至10:30期间去过皮尔逊机场1号航站楼的任何人,都可能接触过麻疹患者。
据PPH称,这种高度传染性的病毒会传播给未接种疫苗或未曾感染过麻疹的人。麻疹症状通常在感染后1至3周内出现,包括高烧、流鼻涕、咳嗽、眼睛红肿流泪、对光敏感,以及持续4至7天的红色皮疹。PPH建议出现任何症状的麻疹病毒潜在接触者立即联系医疗保健提供者或PPH,并且不要上班或上学。
PPH还强调:“即使已经接种麻疹疫苗的人,也应在接触麻疹患者后的21天内注意观察是否出现症状。”PPH建议那些可能接触过病毒的人检查疫苗接种记录,以确认自己是否接种了最新的麻疹疫苗。如果不确定疫苗接种情况,PPH建议联系个人医疗保健提供者。
PPH指出,1岁以下儿童和免疫系统较弱的人群,包括孕妇,面临更高的并发症风险。所有安省居民都可以根据医疗提供者的判断和患者需求,获得一至两剂由政府资助的麻疹疫苗。截止12月4日,安省2024年的麻疹病例总数达到35例,是去年全年病例数的7倍多。其中7人需要住院治疗。
图源:CTV
加拿大9年来最大规模麻疹疫情:1例死亡138例确诊。2024年迄今为止,加拿大全国报告了138例麻疹病例,比去年全年的12例飙增了11倍,是自2015年以来病例数最多的一年。

图源:CTV
加拿大6个省份均报告了麻疹病例,其中新不伦瑞克省47例、安省35例、魁省53例,阿尔伯塔省、BC省和萨斯喀彻温省各1例。

图源:Canada.ca
在全国的138例病例中,10例(7%)为1岁以下婴儿,23例(17%)为1至4岁幼儿,42例(30%)为5至17岁儿童和青少年,61例(44%)为18至51岁成年人,2例(1%)为55岁以上老年人。今年5月,汉密尔顿一名5岁以下儿童死于麻疹,这是安省自1989年追踪麻疹病例以来首次出现死亡病例。

图源:Canada.ca
加拿大被批"太落后"
“这确实很可怕,”加拿大疫苗学中心成员、哈利法克斯IWK健康中心儿科传染病专家Joanne Langley医生说说道。她认为,建立一个全国性登记系统,让人们可以查阅自己的疫苗接种记录以及相关的医疗费用,将有助于提高疫苗接种率,减少麻疹和其他疫苗可预防疾病的发生。同时还可以帮助卫生官员评估疫苗的覆盖率、效果和安全性。
她指出,虽然各省和地区已经改进了疫苗登记系统,但加拿大在整合这些数据、获取全国疫苗接种情况方面"仍然相当落后"。多伦多都会大学职业与公共卫生学院的流行病学家和名誉教授Tim Sly表示,许多国家已经建立类似系统,而在加拿大,“我们还在厨房抽屉里翻找一张小黄卡”。
“这可不行,”Sly说。“在信息技术发达的今天,我们需要一个全国性的数据库来查看谁接种过疫苗。”这对于传染性极强的麻疹尤其重要。Sly表示,为了防止麻疹传播,至少95%的人口需要接种两剂麻疹、腮腺炎和风疹 (MMR) 疫苗。“麻疹是我们已知的最具传染性的疾病之一,即使只有少数人未接种疫苗,也可能爆发疫情,我们知道预防麻疹的最佳方法就是接种疫苗。”
卫生部发言人Tara Chislett表示,在新不伦瑞克省的50例病例中,90%未接种疫苗,其余10%无法提供接种疫苗的证明。加拿大公共卫生局发言人Nicholas Janveau表示,创建一个集中式全国性登记系统面临许多重大挑战,这些挑战“根植于加拿大分散的医疗保健系统的结构、法律和运作现实”。此外,隐私问题也是其中之一,因此各地对隐私管理的规则和方法不同。(据51网、CTV、Canada.ca)